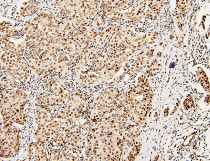

ARG41735
anti-DDX5 / p68 RNA helicase antibody
anti-DDX5 / p68 RNA helicase antibody for Flow cytometry,ICC/IF,IHC-Formalin-fixed paraffin-embedded sections,Western blot and Human,Mouse,Rat
Overview
| Product Description | Rabbit Polyclonal antibody recognizes DDX5 / p68 RNA helicase |
|---|---|
| Tested Reactivity | Hu, Ms, Rat |
| Tested Application | FACS, ICC/IF, IHC-P, WB |
| Host | Rabbit |
| Clonality | Polyclonal |
| Isotype | IgG |
| Target Name | DDX5 / p68 RNA helicase |
| Antigen Species | Human |
| Immunogen | Recombinant protein corresponding to R85-K328 of Human DDX5 / p68 RNA helicase. |
| Conjugation | Un-conjugated |
| Alternate Names | Probable ATP-dependent RNA helicase DDX5; DEAD box protein 5; p68; HUMP68; EC 3.6.4.13; G17P1; RNA helicase p68; HLR1 |
Application Instructions
| Application Suggestion |
|
||||||||||
|---|---|---|---|---|---|---|---|---|---|---|---|
| Application Note | IHC-P: Antigen Retrieval: Heat mediation was performed in Citrate buffer (pH 6.0) for 20 min. * The dilutions indicate recommended starting dilutions and the optimal dilutions or concentrations should be determined by the scientist. |
||||||||||
| Observed Size | ~ 70 kDa |
Properties
| Form | Liquid |
|---|---|
| Purification | Affinity purification with immunogen. |
| Buffer | 0.2% Na2HPO4, 0.9% NaCl, 0.05% Sodium azide and 4% Trehalose. |
| Preservative | 0.05% Sodium azide |
| Stabilizer | 4% Trehalose |
| Concentration | 0.5 mg/ml |
| Storage Instruction | For continuous use, store undiluted antibody at 2-8°C for up to a week. For long-term storage, aliquot and store at -20°C or below. Storage in frost free freezers is not recommended. Avoid repeated freeze/thaw cycles. Suggest spin the vial prior to opening. The antibody solution should be gently mixed before use. |
| Note | For laboratory research only, not for drug, diagnostic or other use. |
Bioinformation
| Database Links |
Swiss-port # P17844 Human Probable ATP-dependent RNA helicase DDX5 |
|---|---|
| Gene Symbol | DDX5 |
| Gene Full Name | DEAD (Asp-Glu-Ala-Asp) box helicase 5 |
| Background | DEAD box proteins, characterized by the conserved motif Asp-Glu-Ala-Asp (DEAD), are putative RNA helicases. They are implicated in a number of cellular processes involving alteration of RNA secondary structure, such as translation initiation, nuclear and mitochondrial splicing, and ribosome and spliceosome assembly. Based on their distribution patterns, some members of this family are believed to be involved in embryogenesis, spermatogenesis, and cellular growth and division. This gene encodes a DEAD box protein, which is a RNA-dependent ATPase, and also a proliferation-associated nuclear antigen, specifically reacting with the simian virus 40 tumor antigen. This gene consists of 13 exons, and alternatively spliced transcripts containing several intron sequences have been detected, but no isoforms encoded by these transcripts have been identified. [provided by RefSeq, Jul 2008] |
| Function | Involved in the alternative regulation of pre-mRNA splicing; its RNA helicase activity is necessary for increasing tau exon 10 inclusion and occurs in a RBM4-dependent manner. Binds to the tau pre-mRNA in the stem-loop region downstream of exon 10. The rate of ATP hydrolysis is highly stimulated by single-stranded RNA. Involved in transcriptional regulation; the function is independent of the RNA helicase activity. Transcriptional coactivator for estrogen receptor ESR1 and androgen receptor AR. Increases ESR1 AF-1 domain-mediated transactivation and ESR1 AF-1 and AF-2 domains transcriptional synergistic activity. Synergizes with DDX17 and SRA1 RNA to activate MYOD1 transcriptional activity and involved in skeletal muscle differentiation. Transcriptional coactivator for p53/TP53 and involved in p53/TP53 transcriptional response to DNA damage and p53/TP53-dependent apoptosis. Transcriptional coactivator for RUNX2 and involved in regulation of osteoblast differentiation. Acts as transcriptional repressor in a promoter-specicic manner; the function probbaly involves association with histone deacetylases, such as HDAC1. As component of a large PER complex is involved in the inhibition of 3' transcriptional termination of circadian target genes such as PER1 and NR1D1 and the control of the circadian rhythms. [UniProt] |
| Cellular Localization | Nucleus, nucleolus. [UniProt] |
| Calculated MW | 69 kDa |
| PTM | Arg-502 is dimethylated, probably to asymmetric dimethylarginine. Sumoylated; sumoylation, promoted by PIAS1, promotes interaction with HDAC1 and transcriptional repression activity. Sumoylation also significantly increases stability, and reduces polyubiquitination. Polyubiquitinated, leading to proteasomal degradation. [UniProt] |
Images (9) Click the Picture to Zoom In
-
ARG41735 anti-DDX5 / p68 RNA helicase antibody ICC/IF image
Immunofluorescence: U2OS cells were blocked with 10% goat serum and then stained with ARG41735 anti-DDX5 / p68 RNA helicase antibody (red) at 2 µg/ml dilution, overnight at 4°C. DAPI (blue) for nuclear staining.
-
ARG41735 anti-DDX5 / p68 RNA helicase antibody IHC-P image
Immunohistochemistry: Paraffin-embedded Rat small intestine tissue. Antigen Retrieval: Heat mediation was performed in Citrate buffer (pH 6.0, epitope retrieval solution) for 20 min. The tissue section was blocked with 10% goat serum. The tissue section was then stained with ARG41735 anti-DDX5 / p68 RNA helicase antibody at 1 µg/ml dilution, overnight at 4°C.
-
ARG41735 anti-DDX5 / p68 RNA helicase antibody WB image
Western blot: 50 µg of samples under reducing conditions. HL-60, A431, U-87MG, K562 and THP-1 whole cell lysates stained with ARG41735 anti-DDX5 / p68 RNA helicase antibody at 0.5 µg/ml dilution, overnight at 4°C.
-
ARG41735 anti-DDX5 / p68 RNA helicase antibody FACS image
Flow Cytometry: HL-60 cells were blocked with 10% normal goat serum and then stained with ARG41735 anti-DDX5 / p68 RNA helicase antibody (blue) at 1 µg/10^6 cells for 30 min at 20°C, followed by incubation with DyLight®488 labelled secondary antibody. Isotype control antibody (green) was Rabbit IgG (1 µg/10^6 cells) used under the same conditions. Unlabelled sample (red) was also used as a control.
-
ARG41735 anti-DDX5 / p68 RNA helicase antibody IHC-P image
Immunohistochemistry: Paraffin-embedded Rat small intestine tissue. Antigen Retrieval: Heat mediation was performed in Citrate buffer (pH 6.0, epitope retrieval solution) for 20 min. The tissue section was blocked with 10% goat serum. The tissue section was then stained with ARG41735 anti-DDX5 / p68 RNA helicase antibody at 1 µg/ml dilution, overnight at 4°C.
-
ARG41735 anti-DDX5 / p68 RNA helicase antibody IHC-P image
Immunohistochemistry: Paraffin-embedded Human intestinal cancer tissue. Antigen Retrieval: Heat mediation was performed in Citrate buffer (pH 6.0, epitope retrieval solution) for 20 min. The tissue section was blocked with 10% goat serum. The tissue section was then stained with ARG41735 anti-DDX5 / p68 RNA helicase antibody at 1 µg/ml dilution, overnight at 4°C.
-
ARG41735 anti-DDX5 / p68 RNA helicase antibody IHC-P image
Immunohistochemistry: Paraffin-embedded Human mammary cancer tissue. Antigen Retrieval: Heat mediation was performed in Citrate buffer (pH 6.0, epitope retrieval solution) for 20 min. The tissue section was blocked with 10% goat serum. The tissue section was then stained with ARG41735 anti-DDX5 / p68 RNA helicase antibody at 1 µg/ml dilution, overnight at 4°C.
-
ARG41735 anti-DDX5 / p68 RNA helicase antibody IHC-P image
Immunohistochemistry: Paraffin-embedded Mouse small intestine tissue. Antigen Retrieval: Heat mediation was performed in Citrate buffer (pH 6.0, epitope retrieval solution) for 20 min. The tissue section was blocked with 10% goat serum. The tissue section was then stained with ARG41735 anti-DDX5 / p68 RNA helicase antibody at 1 µg/ml dilution, overnight at 4°C.
-
ARG41735 anti-DDX5 / p68 RNA helicase antibody WB image
Western blot: 50 µg of samples under reducing conditions. Rat brain, Rat thymus, Mouse brain, Mouse thymus and NIH/3T3 whole cell lysates stained with ARG41735 anti-DDX5 / p68 RNA helicase antibody at 0.5 µg/ml dilution, overnight at 4°C.